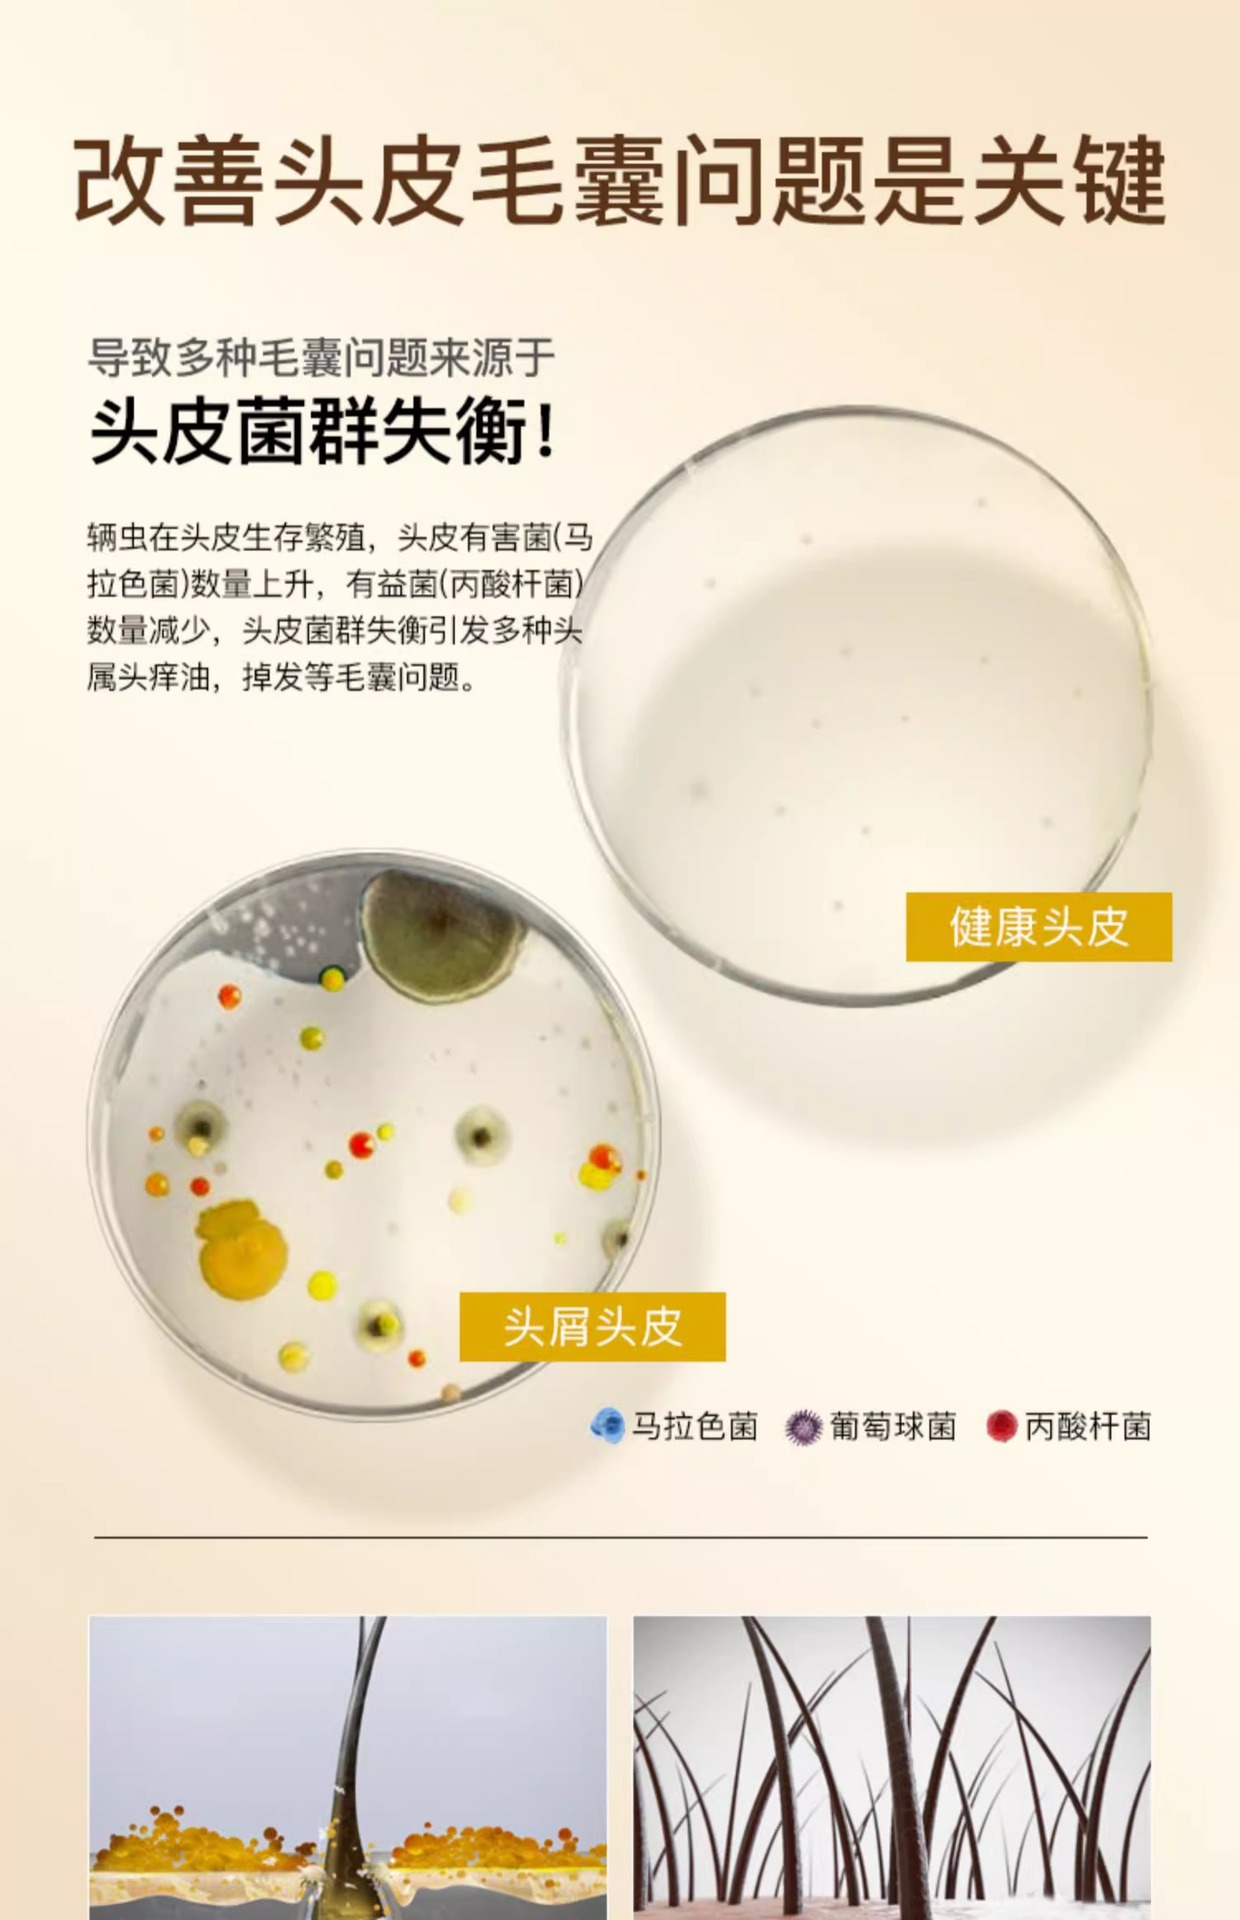

Корректирующий шампунь с селеном дисульфидом, очищающий, против перхоти, контроль масла, объемный, длительный аромат, увлажняющий, питательный, себорейный для мужчин и женщин
Цена
¥21.00 / ≈ 253 ₽
MOQ: 1 pcs
1шт - ¥21.00
Продавец
杭州聚顺福电子商务有限公司
Рейтинг
0
Продано
0
Всего
В наличии
3997
SKU суммарно
Offer ID: 994437276620
Статистика продавца
4.0
Сервис
Источник: API 1688
2.8
Логистика
Источник: API 1688
5.0
Споры
Источник: API 1688
5.0
Оформление
Источник: API 1688
0.0
Консультация
Источник: API 1688
6%
Повторные покупки
Источник: API 1688
5.0
Постпродажное
Источник: API 1688
0%
Возврат по качеству (30д)
Источник: API 1688
Свойства товара
Тип бренда Correction
Происхождение Mainland china
Штрих-код продукта 6975061503408
Подходит для типа волос All hair types
Эффективность Anti-dandruff
Косметика специального назначения No
Тип спецификации Formal wear
Название продукта Selenium disulfide cleansing and anti-dandruff shampoo
Описание товара